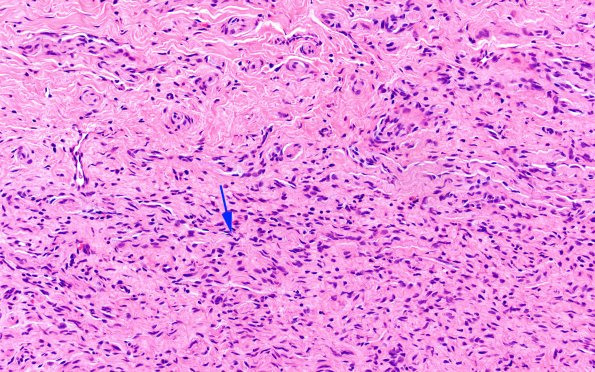
23A4 Neuroma (Case 23) H&E 20X 2 copy

Table of Contents
Washington University Experience | PERIPHERAL NEUROPATHY | 19 TRAUMATIC INJURIES | 23A4 Neuroma (Case 23) H&E 20X 2 copy
In this image, there are mini-fascicles accompanied by an area with a smaller portion of the tissue showing an abnormal region (arrow) in which there is more solid growth. (H&E)